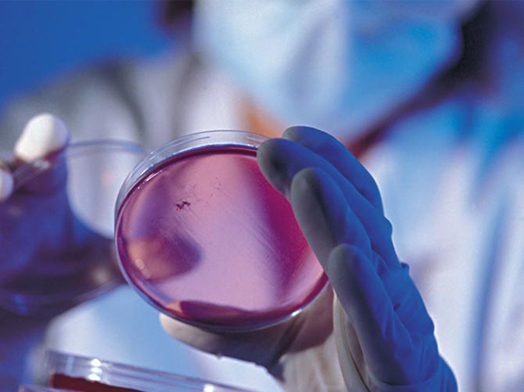

联系我们 / CONTACT

咨询热线18384106284
- 手机:028-83319491
- 邮箱:3177925618@qq.com
- 地址:四川省成都市成华区羊子山路68号
单胃动物对淀粉的消化吸收
日期:2021-11-30
信息摘要:
单胃动物对淀粉的消化起始于口腔,淀粉在唾液淀粉酶的作用下被部分分解成部分糊精和少量麦芽糖
单胃动物对淀粉的消化起始于口腔,淀粉在唾液淀粉酶的作用下被部分分解成部分糊精和少量麦芽糖,但食物在口腔中停留的时间很短且唾液淀粉酶活性很低,故唾液对淀粉的消化非常有限。胃内不分泌淀粉酶,但唾液淀粉酶可在胃内对淀粉持续消化一段时间。
小肠是淀粉消化的主要场所,大部分淀粉的消化吸收是在小肠中进行的。饲料淀粉在十二指肠与胰液、肠液、胆汁混合后,在α-淀粉酶的作用下,直链淀粉被逐步分解为麦芽糖和麦芽三糖,支链淀粉被分解为麦芽糖、麦芽三糖和α-ji限糊精。α-ji限糊精在异麦芽糖酶(α-1,6糖苷酶)的作用下被分解成麦芽糖和葡萄糖。麦芽糖、麦芽三糖在麦芽糖酶的作用下被分解成葡萄糖而被肠壁吸收。
文章转自:https://www.cnenzyme.com/news/show-1601.html
部分图文转载自网络,版权归原作者所有,如有侵权请联系我们删除。如内容中如涉及加盟,投资请注意风险,并谨慎决策
查看更多 / more
